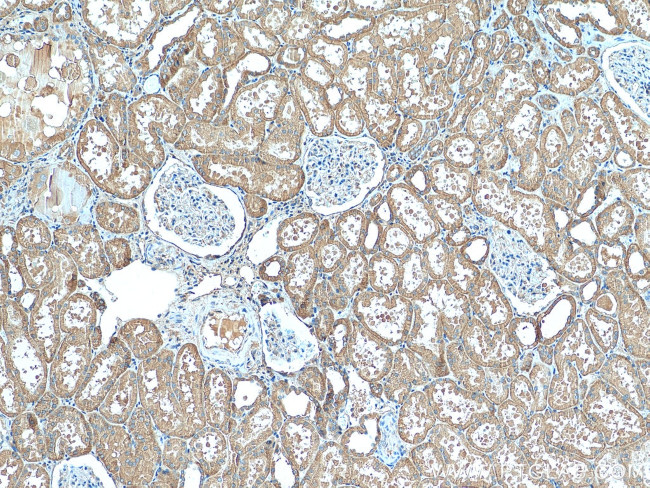
TMOD3 Antibody in Immunohistochemistry (Paraffin) (IHC (P))

Search
Proteintech
TMOD3 Polyclonal Antibody
{{$productOrderCtrl.translations['antibody.pdp.commerceCard.promotion.promotions']}}
{{$productOrderCtrl.translations['antibody.pdp.commerceCard.promotion.viewpromo']}}
{{$productOrderCtrl.translations['antibody.pdp.commerceCard.promotion.promocode']}}: {{promo.promoCode}} {{promo.promoTitle}} {{promo.promoDescription}}. {{$productOrderCtrl.translations['antibody.pdp.commerceCard.promotion.learnmore']}}
产品信息
12521-1-AP
种属反应
宿主/亚型
分类
类型
抗原
偶联物
形式
浓度
规格
纯化类型
保存液
内含物
保存条件
运输条件
产品详细信息
Immunogen sequence: MALPFRKDL EKYKDLDEDE LLGNLSETEL KQLETVLDDL DPENALLPAG FRQKNQTSKS TTGPFDREHL LSYLEKEALE HKDREDYVPY TGEKKGKIFI PKQKPVQTFT EEKVSLDPEL EEALTSASDT ELCDLAAILG MHNLITNTKF CNIMGSSNGV DQEHFSNVVK GEKILPVFDE PPNPTNVEES LKRTKENDAH LVEVNLNNIK NIPIPTLKDF AKALETNTHV KCFSLAATRS NDPVATAFAE MLKVNKTLKS LNVESNFITG VGILALIDAL RDNETLAELK IDNQRQQLGT AVELEMAKML EENTNILKFG YQFTQQGPRT RAANAITKNN DLVRKRRVEG DHQ (1-352 aa encoded by BC020542)
靶标信息
Blocks the elongation and depolymerization of the actin filaments at the pointed end. The Tmod/TM complex contributes to the formation of the short actin protofilament, which in turn defines the geometry of the membrane skeleton.
仅用于科研。不用于诊断过程。未经明确授权不得转售。
生物信息学
蛋白别名: actin filament pointed-end capping protein; tropomodulin 3 (ubiquitous); tropomodulin 3; ubiquitous tropomodulin; Tropomodulin-3; U-Tmod; Ubiquitous tropomodulin; unnamed protein product
基因别名: TMOD3; U-Tmod; UTMOD
UniProt ID: (Human) Q9NYL9, (Mouse) Q9JHJ0
Entrez Gene ID: (Human) 29766, (Mouse) 50875, (Rat) 300838